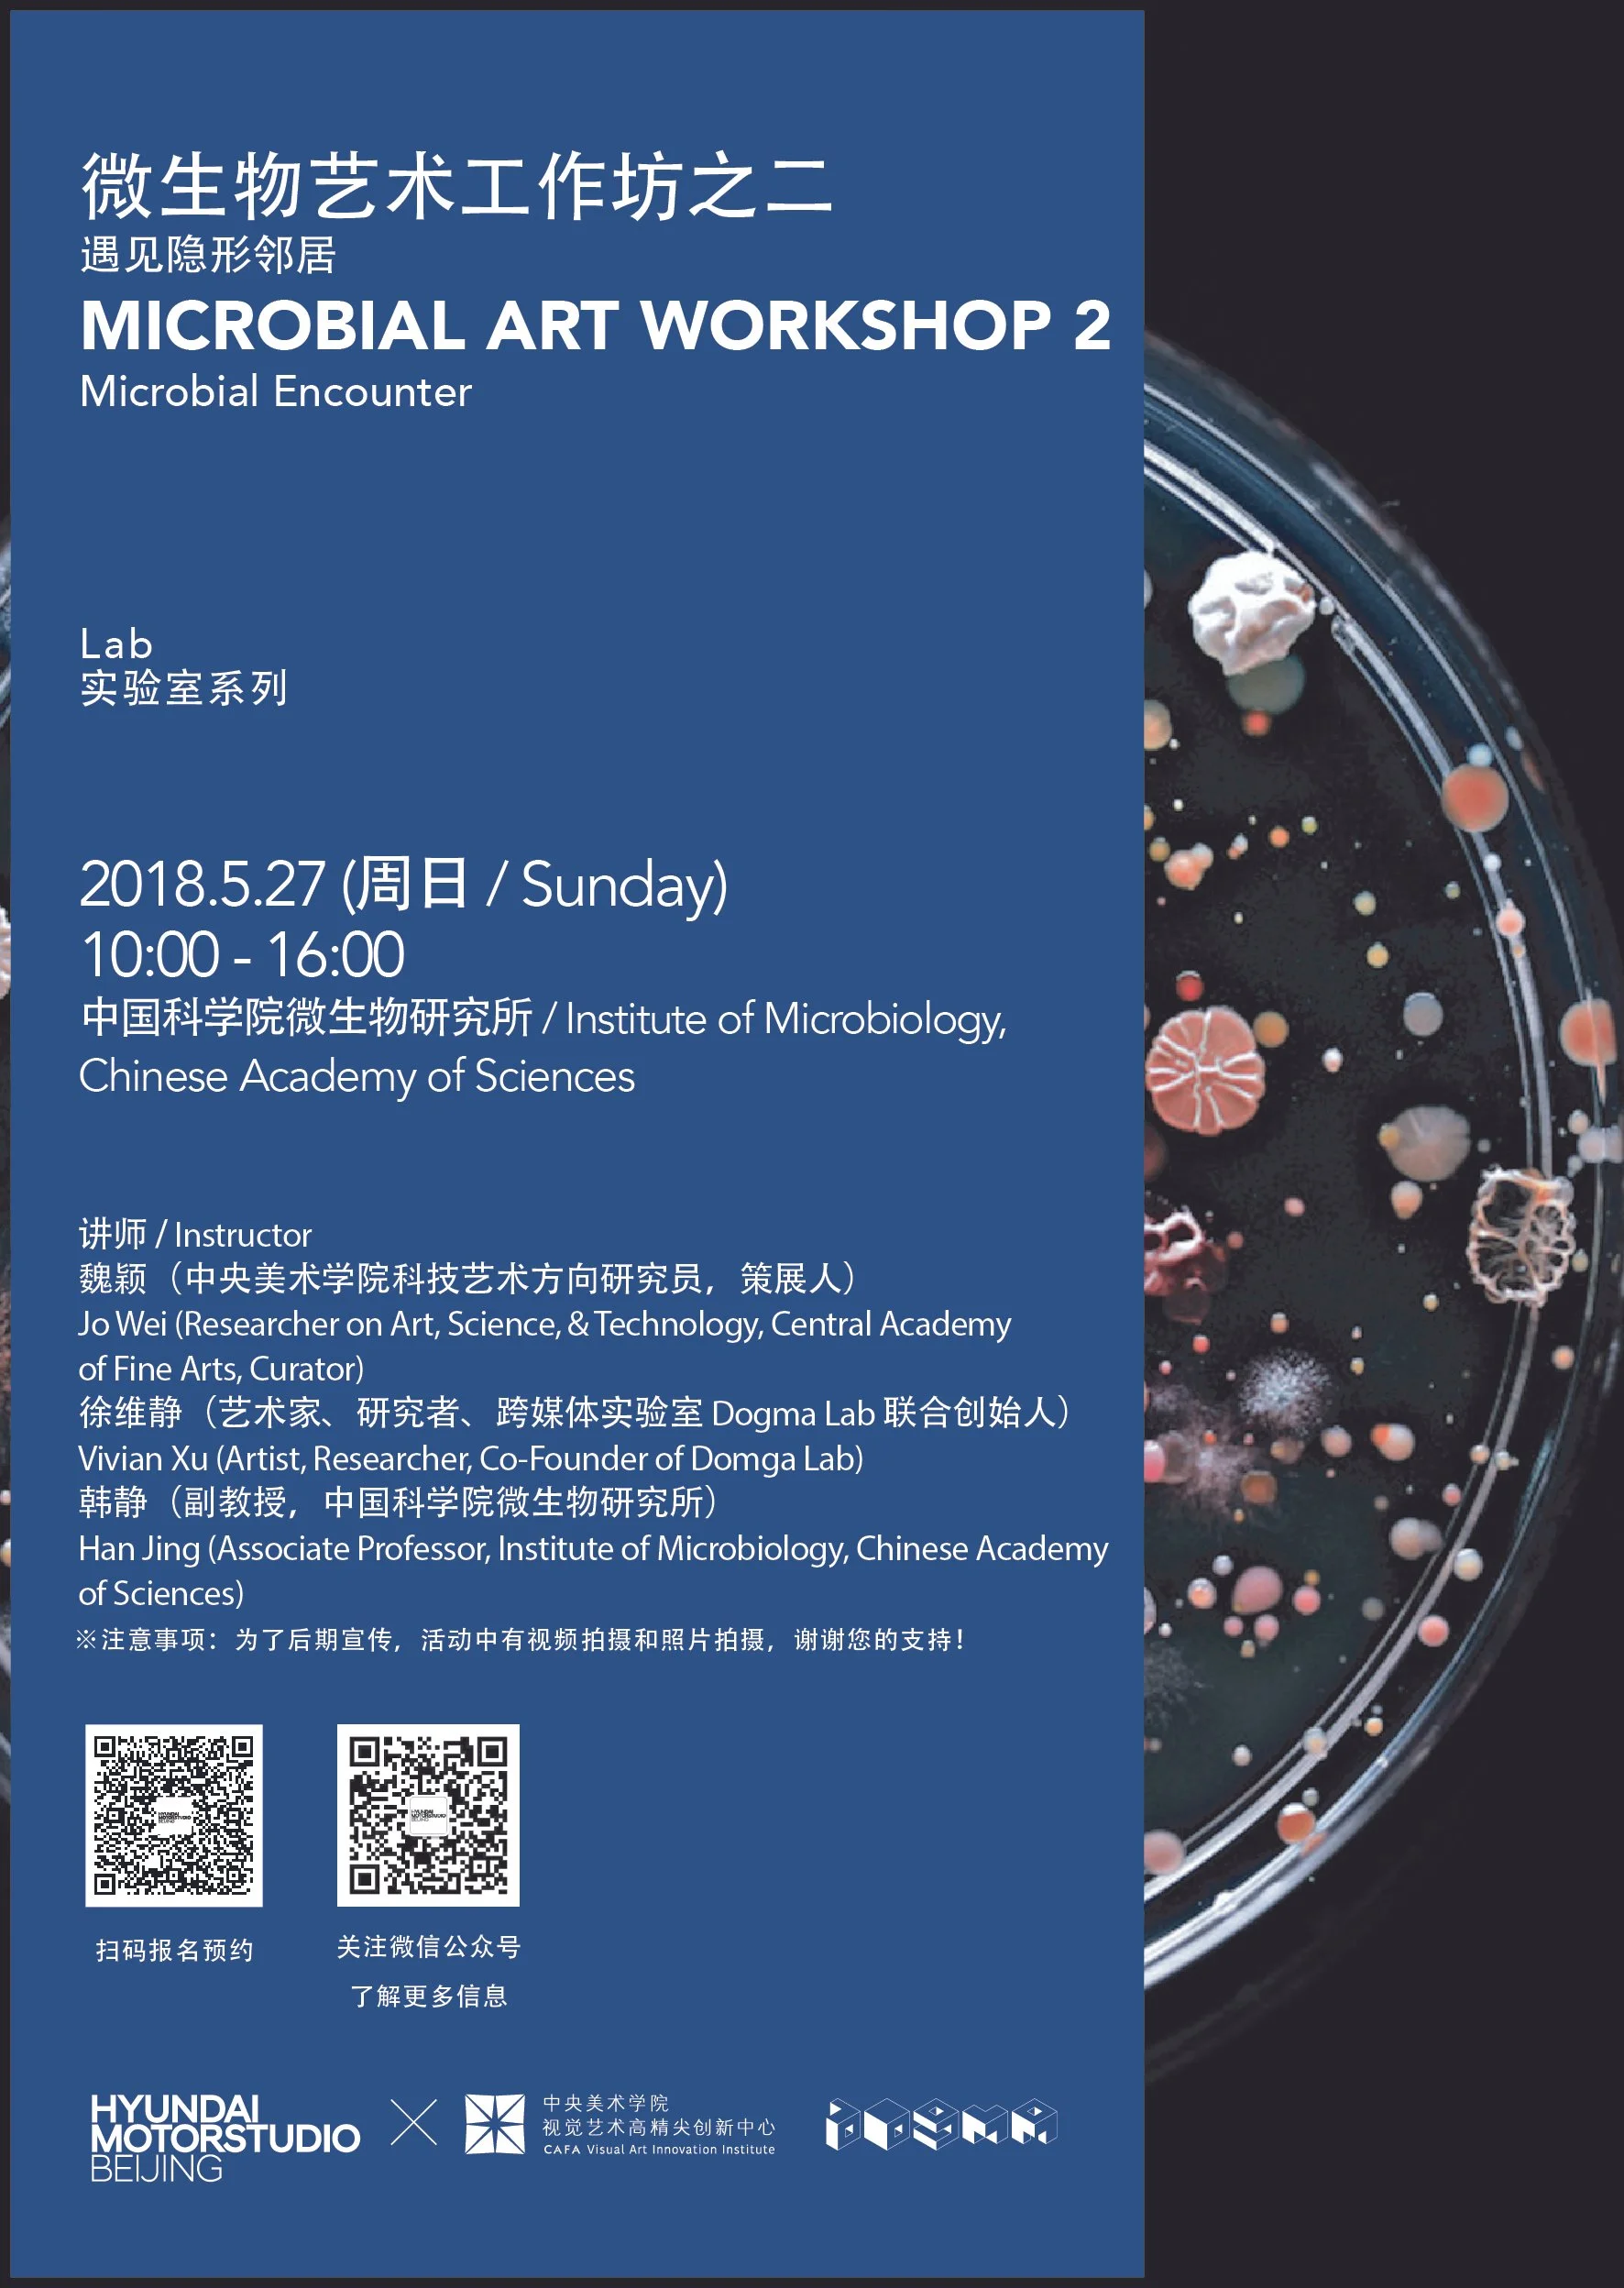

Workshop | 工作坊
-

BioArt Workshop
CAFA & Chinese Academy of Sciences & Kac Studio
-
Microbial Art Workshop
—Kombucha as Future Material
CAFA & Hyundai Motorstudio BJ
-
Microbial Art Workshop
—Microbial Encounter
CAFA & Hyundai Motorstudio BJ
-

The History of AST Workshop
CAFA
-

Gene Editing & Art Workshop
CAFA & Peking University